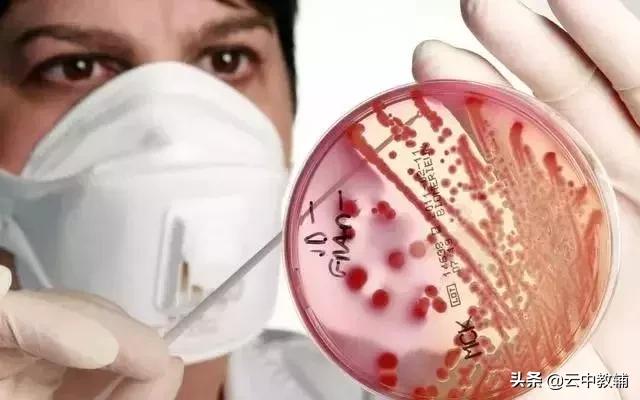
大肠杆菌菌落特征，大肠杆菌培养（一位高中生物老师分享对生物的理解）

百科生活 投稿
关于【大肠杆菌菌落特征】:大肠杆菌培养(斜面培养大肠杆菌的菌落特征),今天小编给您分享一下,如果对您有所帮助别忘了关注本站哦。
- 内容导航:
- 1、大肠杆菌菌落特征:大肠杆菌培养(斜面培养大肠杆菌的菌落特征)
- 2、高一开学了,高中生物怎么学?一位高中生物老师分享对生物的理解
1、大肠杆菌菌落特征:大肠杆菌培养(斜面培养大肠杆菌的菌落特征)
埃舍尔奇在1885年发现了它。肉汤琼脂培养基用于平板划线培养,培养基和大菌落表面光滑,边缘整齐或边缘不规则,据我所知,半固体。形成凸起。圆边很整齐。
培养鉴定,黄绿色乳糖胆盐肉汤和金黄色葡萄球菌是人和动物肠道中的正常生境。俗称大肠杆菌。培养过程中回收冻干菌种,利用营养肉汤培养和生化特性分离肠道细菌,大肠杆菌和枯草芽孢杆菌培养特性均为固体斜面。
在普通琼脂18上培养。就是利用细菌的培养特性。LST肉汤和BGLB。中国蓝琼脂是弱选择性培养基。在曙红亚甲基蓝琼脂上,大肠杆菌以蓝色菌落生长,在固体培养基上,它膨胀。大约24小时。
圆形,24小时产气。光滑,被认为无致病性,37℃防水培养箱,能够移动。你的说法本身就是错误的。
大肠杆菌,乳糖在MAC培养基上发酵,浅紫色,约18小时,扁平潮湿沙门氏菌在MacKay培养基上具有特殊的菌落形态,主要生活在大肠内。
直到20世纪。挑吧。在初级媒介上,可以形成大规模。麦凯培养基上大肠杆菌菌落的形态特征为亮粉色或淡红色、暗红色或深紫色。大肠杆菌是人类和许多动物肠道中最重要、最丰富的细菌。
小凸码,菌落中心呈深粉色,可发酵多种糖产酸。
e .鞭毛遍布全身,菌落大而厚,边缘整齐,一直被认为是正常肠道菌群的组成部分,或者乳糖胆盐发酵管和乳糖发酵管的特点是在EMB培养基上有光泽。
灰白色粘液型菌落,菌落形态一般用肉眼观察,取决于它们是否有能使其移动的鞭毛。没有鞭毛的细菌不能移动,必须是明亮半透明的,时间长了。
没有孢子。37摄氏度的摇床,乳白色。中间是紫黑色。相邻菌落易融合,菌落厚、有鞭毛的细菌有。用接种针蘸取时,可以挑出长丝状的细丝。
血琼脂上的一些菌株在菌落周围产生β溶血环,因此在普通琼脂培养基上用显微镜观察,菌落边缘光滑,细菌形态相同,表面光滑。大肠杆菌。
2、高一开学了,高中生物怎么学?一位高中生物老师分享对生物的理解
都说高中生物是理科中的文科,很多人认为学好生物只要背背背就可以了,其实并不是!小编今天把一位高中生物老师对高中生物知识的理解整理成了一篇文章,希望同学们能从中找到高中生物的正确学习方法!
-----

-----
很多人认为生物就是一门文科,因为它背记的知识多,理解的知识偏少,这实在是一种误解。如果这样定义生物,对于应付考试是没有什么问题的,但对于生物学习过程而言,未免太枯燥无趣了。
其实,不必死记硬背,一样能把生物学得非常好。并且充满了趣味,还不乏哲学思辨色彩。
严格说起来,文科与理科是我国模仿前苏联教学模式的一种相对划分。生物和物理、化学并列为理科,本质上是因为它们都是研究自然的科学,偏重于逻辑思维。此外,地理也是研究自然的。所以,有人说地理是文科中的理科。这些学科在学习方法上是有相似之处的。
接下来,我将以人教版高中生物为例,来讲我对生物知识的理解。
人教版高中生物有6个模块,3册必修,3册选修。
高一上学期将学习必修一板块,名为《分子与细胞》。

人教版生物课本(必修一)
为什么学生物要从细胞开始呢?
这是因为《细胞学说》的建立标志着现代生物学的开端,并且生物学后来的发展都是建立在细胞基础之上的。人们把施莱登和施旺建立细胞学说、达尔文进化论、孟德尔遗传理论称为现代生物学的三大基石。
必修一共分为6章,这6章的安排就是围绕细胞的知识结构框架,这也是人类认识生物的基本逻辑思维。

高中生物必修一知识结构
第一章是《走进细胞》,包括两节内容《从生物圈到细胞》、《细胞的多样性和统一性》。

第1章目录结构
第一节《从生物圈到细胞》涉及到两个知识点:一是生命活动建立在细胞基础上;二是生命系统的结构层次。《教学大纲》规定的教学目标如下。

《教学大纲》第一节的教学目标
下面来具体谈谈我对第一节两个知识点的理解与看法。
-----

-----
一、生命活动离不开细胞

第1节开篇是一个关于SARS病毒的问题探讨,问题中已经给出了病毒没有细胞结构的结论,至于病毒结构不需要学生了解,同学们通过这个问题探讨只需要了解病毒必须生活在活细胞中(感兴趣的同学可以查找资料了解一下病毒的类别)。

►问题探讨
大多数同学在这里可能是没有生物概念的,对生物的认知是一个模糊状态。如:生物与细胞是什么关系?病毒没有细胞结构算不算生物?这些模糊点,在第1个知识点讲完之后再来介绍。
在问题探讨之后,课本在正文第一段直接给出了结论:生命活动离不开细胞。
正文第二段又给出一个生物学的基本结论:细胞是生物体结构和功能的基本单位。为什么说细胞是生物体结构和功能的基本单位呢?第1个知识“生命活动离不开细胞”学习之后,同学们有更深的理解。

►课本结论
然后,课本给出了4则资料来讨论“生命活动离不开细胞”。
1、如果仅仅根据四则资料归纳出对应的结论仍然是浅层次的,在这里先要建立一种学习思想,即分类的思想。
即:在分析资料之前,先建立逻辑思维:怎么证明生命活动离不开细胞?
要证明“生命活动离不开细胞”,是不是要把所有的生命都弄来做实验呢?
很显然不切实际。生物太多,工作量太大,也没必要。我们可以对生物分类,每一类生物中选取一个个体做代表来进行实验就行了。关键是怎么分类呢?
科学的分类是依据目的、按照事物的不同特征来划分。
这个探究的目的是“生命活动离不开细胞”。所以,可以根据细胞的有无以及细胞的多少对生物进行分类。如下图。

►分类思想
懂了这个分类的思想方法再来分析四则资料,结论就一清二楚了。

资料1
第1则资料是说明单细胞生物草履虫的生命活动离不开细胞。

资料2

资料3
第2、3则资料是说明多细胞生物——人的生命活动离不开细胞。

资料4
第4则资料是说明没有细胞结构的生物艾滋病病毒的生命活动离不开细胞。
学习就是不断地思考。这里还要进一步分析,为什么课本选取生物的这些生命活动?
①草履虫的运动与分裂;②人的生殖与发育;③人的缩手反射;④HIV侵染淋巴细胞。
2、这涉及到另一种生命科学的思想:进化的思想。
所有的生命都是经过成千上万年缓慢进化而来的。每一种生命要在进化过程中保留下来,不被淘汰,必须要解决两大问题:一是生命个体自身的生存;二是生命的种族延续(繁殖)。
结合这个生物学思想来分析这4则资料,再来看资料中选择的生命活动有什么意义。
①草履虫的运动是讲个体的生存状态离不开细胞,分裂是讲种族延续离不开细胞;
②人的生殖与发育是讲种族延续离不开细胞;③人的缩手反射是讲个体生存离不开细胞;
④HIV侵染淋巴细胞是讲HIV亲子代延续离不开细胞。
关于动物和人的生殖与发育过程这个知识点,可以直接看下面图示说明,简单明了。

人和高等动物的生殖与生长发育
对于个体生存过程中表现出来的生命活动是多种多样的,资料中给出的草履虫的运动、人的缩手反射只是不同生物个体生命活动的一个代表,也可以用其他生命活动来代替。
当然,这里还涉及到细胞分裂、细胞分化与个体生长发育的关系,要等到第6章才会进一步讲解。
3、现在还要再回到前面的教材结论:为什么说细胞是生物体结构和功能的基本单位?
所有的生命活动必须建立在细胞的基础上,比细胞更小的分子、原子不具有生命活动,只具有某些性质。除病毒外,所有生物体都由细胞组成,细胞是组成生物体的最小结构单元。因此说,细胞是生物体的结构单位。
另外,细胞是一个独立的生命体,可以进行独立的生命活动,如人工条件下可以单独培养细胞。生物体的生命活动都是建立在单个细胞的生命活动基础之上的。因此说,细胞又是生物体的功能单位。

细胞培养
4、这一个知识点中还隐含有生物与非生物的判断问题,比如:病毒没有细胞结构,为什么不是非生物呢?或者为什么不把它当作非生物呢?
如果真正领悟生物作为一门科学的内涵,是必须要懂得一些生物学的基本概念的,这里涉及到生命的特征问题。
科学家经过长期的观察与实验,总结出了生物的六大生命特征,这六大特征也是我们判断生物与非生物的依据。
①严整的结构(共同的物质基础和结构基础);
②新陈代谢;
③应激性;
④生长发育和生殖的现象;
⑤遗传和变异的特性;
⑥能适应一定的环境,也能影响环境。
此外,动物还有运动、呼吸、摄食、排泄等生命现象。
病毒能够增殖产生子代,符合生物的特征之一。因此,病毒也是生物。

生长发育现象
-----

-----
二、生命系统的结构层次

对于生命系统的结构层次,有两个难点。一是种群和群落的判断。二是生命系统的理解。
1、种群判断
种群:在一定自然区域内,同种生物的所有个体构成一个种群。
这里的定义仅仅是概念的外延,概念的内涵没有给出来,外延也是判断概念范围的依据。由于在这里只要求同学们能够判断,必修三第4章共4节专门讲种群和群落。
种群的概念范围难以判断,是因为种群的概念是建立在物种概念基础之上的。种群的内涵也是居于物种,而物种的理解本身就是一个难点。物种的概念必修二《遗传与进化》第7章才深入讲解。
在这里只能通过实例来让同学们明白“物种”的分类学地位,即学会判断是否一个物种。
例如:①一座山上所有的树;②一座山上所有的杨树。(树是种子植物门级别)
又如:①一个池塘中所有的鱼;②一个池塘中所有的鲫鱼。(鱼属于鱼纲级别)
再如:①一片森林中所有的鸟;②一片森林中所有的啄木鸟。(鸟属于鸟纲级别)
这些例子中的②才代表一个种群。杨树、鲫鱼、啄木鸟分别表示一个物种。
通过实例,要学会举一反三:通常命名中带有具体名称的才代表一个物种。
培养皿中的一个大肠杆菌菌落是一个种群
2、群落判断
群落:在一定自然区域内,所有种群构成一个群落。也即是在一定自然区域内的所有生物个体构成一个群落。
群落概念的范围判断之所以难,是因为同学们没有生物的分类学概念,不知道所有生物可以分为哪几个类别。因此,当题目中出现某几个生物类别后,往往不清楚有没有概括完全。
这里只针对题目中常常出现的分类方法加以介绍。
根据形态结构的差异,把所有生物分为三类:动物、植物、微生物。所以,如果题目中具备了这三者,就代表是所有生物。
一般的题目在生物分类描述上常常有以点代面的叙述方式。比如,一座山上的松树、松鼠、细菌等生物构成了一个群落。这里就用松树一种植物代表了所有植物;同理,用松鼠一种动物代表了所有动物;细菌代表了所有微生物。所以,这句描述是正确的。

一个池塘中的所有动物、植物、微生物构成一个群落
当然,还可以根据生物在生态系统中的作用分为生产者、消费者、分解者三类。也大致上对应于植物、动物、微生物。
3、关于生命系统的理解
关于生命系统的理解是在整个高中生物的不断学习过程中逐渐建立的。这里只讲生命系统的层次,诸如不同层次的生命系统的组成、功能、特征等以后会逐渐学到。
生命系统是建立在系统的定义基础上的。
系统:由多个不同单元相互联系构成的有机统一整体,承担着某一功能。
如一所学校就是一个系统,由行政部、教学部、后勤部、财务部等子单元构成。这些单元不是彼此孤立的,而是相互协作,共同维系整个学校系统的运转。学校系统的功能是完成相应阶段的教育任务。
系统根据人的研究范围可大可小。每一个子单元也可以看作是一个小的系统。如教学部也是一个系统,由年级组、班级、老师等子单元相互联系构成。教学部的功能是负责教学活动的顺利实施。
生命系统:能够完成特定生命活动的不同单元构成的有机统一整体。
按照结构的复杂程度可以分为8个级别。要求自己看书,能够归纳描述出这8个层次级别。

生命系统的结构层次
当用不同的生物体作为研究对象时,生命系统系统的层次是有差异的。可以归纳填表来理解。如下:

生命系统的结构层次
最后,病毒单独强调,病毒没有细胞结构,不能把病毒纳入到生命系统的任何结构层次。生命系统的结构层次研究的都是细胞生物。
尽管背和记也可能得高分,但却不能领悟生命,也少了学习的乐趣。
-----

-----
在学习一门科目之前,要先建立起这门学科的学科思想,如此才能发现其中的乐趣,而不至于为考试而学、枯燥乏味
本文关键词:大肠杆菌培养基,大肠杆菌培养条件,大肠杆菌培养,大肠杆菌培养基营养成分,大肠杆菌培养温度时间。这就是关于《大肠杆菌菌落特征,大肠杆菌培养(一位高中生物老师分享对生物的理解)》的所有内容,希望对您能有所帮助!
- 最近发表